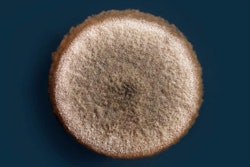
Aspergillus niger colony on an agar plate | Pelooyen | BigStockPhoto

In an experiment, pet food extrusion energy use increased when insoluble fiber was added to dog food recipes, and this should be considered in the overall product price along with raw materials costs, said Aulus Carciofi, PhD, veterinary science researcher at Sao Paulo State University in Brazil.
“Fiber is a hard material with little plasticity and with water binding properties,” Carciofi told Petfood Industry. “Due to this, it reduced the flowing properties of the material, increasing mass resistance and electric energy consumption.”
Fiber in dog food extrusion experimental design
In Carciofi’s experiment dog food formulated with wheat bran, sugarcane fiber and guava fiber all increased dough’s resistance to flow, which increased electricity use by a single-screw extruder machine. All three also created denser harder kibbles than control recipes without the insoluble fibers. The results of the experiment were published in Animal Feed Science and Technology.
Conteracting the effects of fiber in dog food extrusion
Considering the results of his research, pet food product developers and formulators may find it important to study certain pet food extrusion processing parameters, he said. Specifically, the mass moisture (in barrel moisture) and thermal energy application are important.
“Higher thermal energy and moisture could help mass flow, reducing shear, equipment wear and compensate for a potential reduction in starch cooking after fiber inclusion,” Carciofi said. “In addition, insoluble fibers change kibble macrostructure, inducing axial instead radial expansion, and increasing kibble density and hardness.”
This increased hardness and lower expansion can reduce palatability, he said. Due to this, he advised pet food formulators and product developers to mind extruder operation conditions and the quality of the starch to increase kibble quality.